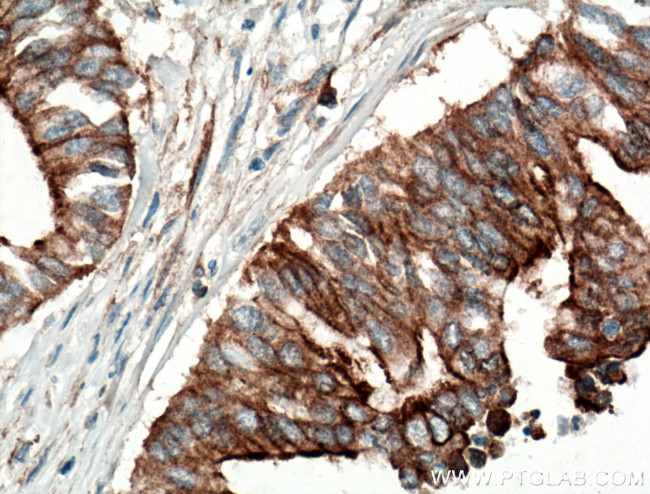
CCDC5 Antibody in Immunohistochemistry (Paraffin) (IHC (P))

Search
Proteintech
CCDC5 Polyclonal Antibody
{{$productOrderCtrl.translations['antibody.pdp.commerceCard.promotion.promotions']}}
{{$productOrderCtrl.translations['antibody.pdp.commerceCard.promotion.viewpromo']}}
{{$productOrderCtrl.translations['antibody.pdp.commerceCard.promotion.promocode']}}: {{promo.promoCode}} {{promo.promoTitle}} {{promo.promoDescription}}. {{$productOrderCtrl.translations['antibody.pdp.commerceCard.promotion.learnmore']}}
产品信息
11094-2-AP
种属反应
宿主/亚型
分类
类型
抗原
偶联物
形式
浓度
规格
纯化类型
保存液
内含物
保存条件
运输条件
产品详细信息
Immunogen sequence: MEPQEERET QVAAWLKKIF GDHPIPQYEV NPRTTEILHH LSERNRVRDR DVYLVIEDLK QKASEYESEA KYLQDLLMES VNFSPANLSS TGSRYLNALV DSAVALETKD TSLASFIPAV NDLTSDLFRT KSKSEEIKIE LEKLEKNLTA TLVLEKCLQE DVKKAELHLS TERAKVDNRR QNMDFLKAKS EEFRFGIKAA EEQLSARGMD ASLSHQSLVA LSEKLARLKQ QTIPLKKKLE SYLDLMPNPS LAQVKIEEAK RELDSIEAEL TRRVDMMEL (1-278 aa encoded by BC014003 )
靶标信息
Contributes to mitotic spindle assembly, maintenance of centrosome integrity and completion of cytokinesis as part of the HAUS augmin-like complex.
仅用于科研。不用于诊断过程。未经明确授权不得转售。
生物信息学
蛋白别名: coiled-coil domain containing 5; coiled-coil domain containing 5 (spindle associated); Coiled-coil domain-containing protein 5; Enhancer of invasion-cluster; HAUS augmin-like complex subunit 1; HEI-C; spindle associated; unnamed protein product
基因别名: BC024400; CCDC5; HAUS1; HEI-C; HEIC; HsT1461
UniProt ID: (Human) Q96CS2, (Rat) Q9R0A8, (Mouse) Q8BHX1
Entrez Gene ID: (Human) 115106, (Rat) 192228, (Mouse) 225745